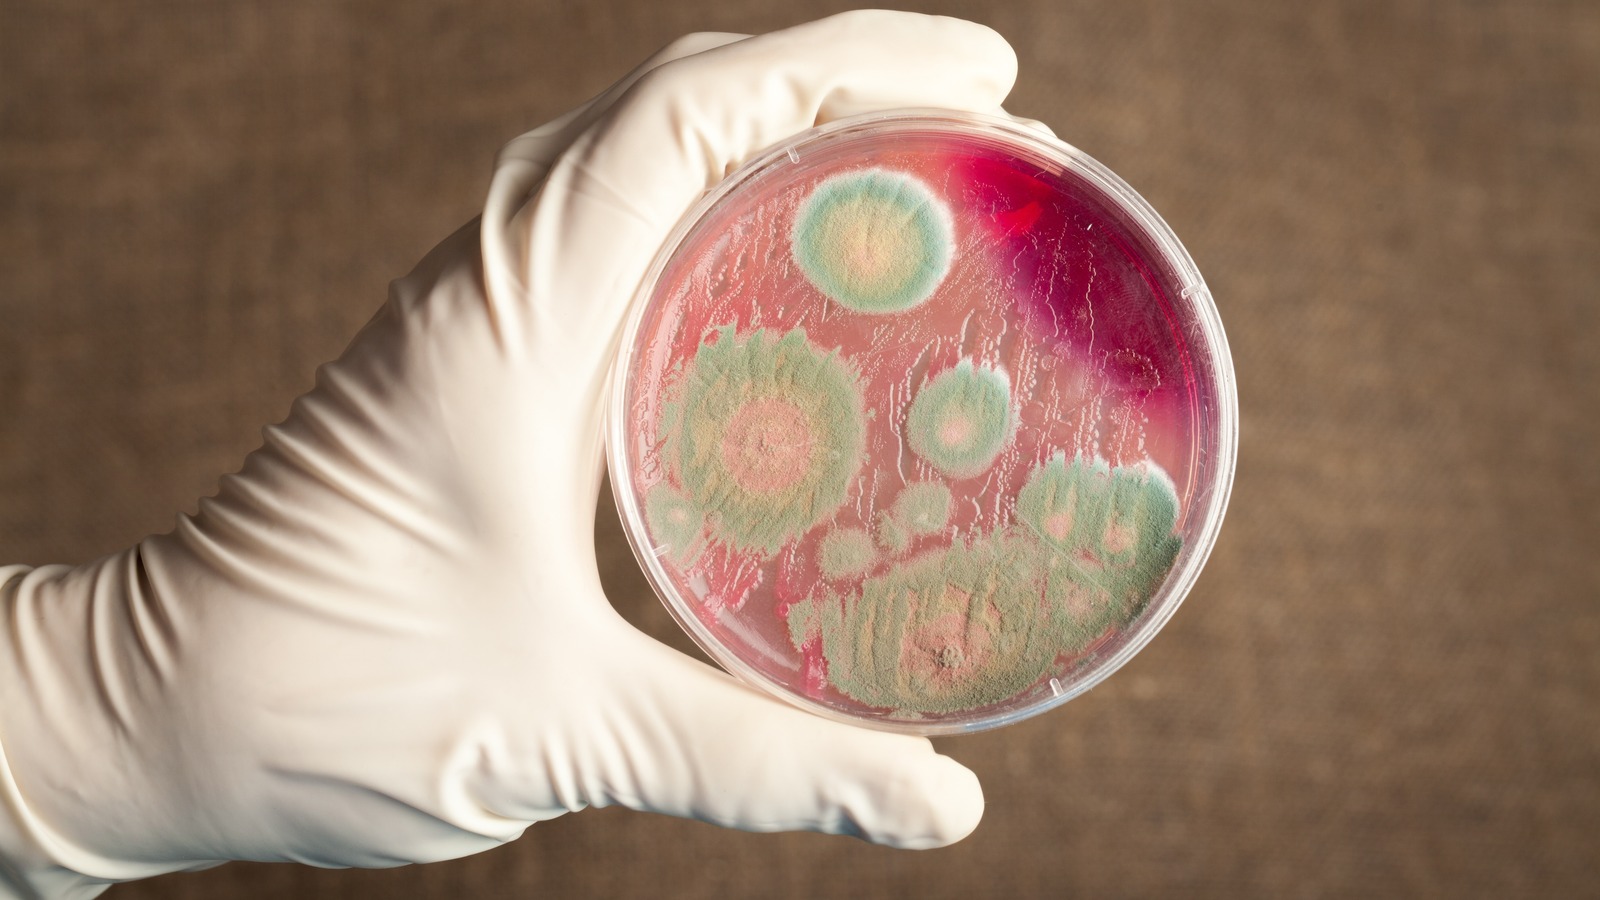

Облыста 122 сібір жарасы көміндісі бар. Былтыр 968 сынама алынып, тексерілді, деп хабарлайды «Тілші» ҚазАқпаратқа сілтеп.
Ветеритария, эпидемилогия қызметі жыл сайын сібір жарасы көмінділерінің орнын тексеріп, топырақтан сынама алады. Былтыр мыңға жуық сынама тексерілді.
– Облыс бойынша 56 типтік мал қорымы бар. Биыл мал қорымы мен сібір жарасы көмінділерін ветеритариялық-санитарлық талапқа сәйкес күтіп ұстауға 18,8 млн теңге жұмсалады. Қазіргі кезде қаржы бөлінді, — деді Ақтөбе облытық ветеринария басқармасының басшысы Айбек Сембай.
Сібір жарасы көміндісінің орны жыл сайын тексеріледі. Оның бүлінген жері жөнделеді, тазалығын қамтамасыз етеді.
– Санитарлық аумағы – 1 000 метр. Осы арақашықтық сақталуы тиіс және өңірде бұл талап сақталған. Егер қандай да бір құрылыс жоспарланса, алдын ала рұқсат сұрайды, — деді Айбек Сембай.